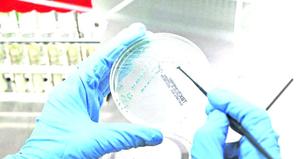

Más leídas

Actualidad | Pág. 2
Mayores de 40 son los que más votan, pero los jóvenes podrían dar sorpresa

Actualidad | Pág. 6
Proyectos ingresados al SEA crecieron el último año

Actualidad | Pág. 6
Jueces del TER escucharon alegatos por acusación contra alcaldesa suspendida

Actualidad | Pág. 6
En cinco años la región registra 2.281 Acuerdos de Unión Civil

Actualidad | Pág. 7
Victimización cae a nivel más bajo en 20 años y aumentan quienes toman medidas para evitar delitos

Actualidad | Pág. 7
Amplían detención del presunto autor de crimen en Calama

Actualidad | Pág. 7
Agrecu exige pago de $50 mil a cada consumidor por colusión del pollo

Actualidad | Pág. 4
20 mil personas se han recuperado del covid en ocho meses de pandemia

Actualidad | Pág. 4
Asistentes de aula llegaron a acuerdo con Cmds y firmaron convenio colectivo

Actualidad | Pág. 4
Farmacia comunal habilita delivery de medicamentos para usuarios postrados

Actualidad | Pág. 4
Hospital capacitó a Carabineros en nuevo protocolo para tratar violencia de género
Actualidad | Pág. 5
Piñera llama "a no bajar los brazos"

Actualidad | Pág. 5
Seremi difunde consejos para evitar contagios en el plebiscito

Actualidad | Pág. 5
Ministro Paris dice que no puede dar correos "si los piden al voleo"
Opinión | Pág. 12
Fernando de Magallanes

Opinión | Pág. 12
La riqueza de Mejillones: su gente, sus líderes

Opinión | Pág. 12
Mis razones del Apruebo

Contraportada | Pág. 20
"Cualquier espacio es el mejor si estás en paz"

Actualidad | Pág. 3
Plebiscito: habilitarán 2 mil servicios gratuitos para transporte de votantes
Actualidad | Pág. 3
Oposición no hará cierre conjunto

Actualidad | Pág. 3
PDI detuvo a ingeniero por ataque a web del gobierno

Actualidad general | Pág. 10
Muere voluntario de vacuna y en Italia el virus está fuera de control

Actualidad general | Pág. 10
El último debate entre Trump y Biden será con los micrófonos silenciados para que no se interrumpan

Actualidad general | Pág. 10
Presentan nueva moción para destituir al presidente de Perú

Actualidad general | Pág. 10
Temen decenas de muertes por protestas en Nigeria
Actualidad general | Pág. 10
Fernández quiere acompañar a Evo Morales en su retorno a Bolivia

Opinión | Pág. 13
Comentarios en la web
Opinión | Pág. 13
Nuestro archivo
Opinión | Pág. 13
Correo
Opinión | Pág. 13
En Twitter: #Magallanes

Actualidad general | Pág. 8
Logran exitosa primera reproducción de ejemplares cautivos de la ranita del Loa

Actualidad general | Pág. 9
Más de 540 niños siguen separados de sus familias tras ser deportadas
Actualidad general | Pág. 9
conexión chilena

Actualidad general | Pág. 9
Francisco, por primera vez, a favor de la unión de homosexuales
Actualidad general | Pág. 11
Detectan marcadores de cáncer de mama

Actualidad general | Pág. 11
Descubren cómo el melanoma "engaña" al sistema inmunológico
Servicios | Pág. 16
Fundación de Antofagasta

Espectáculos | Pág. 19
Cinta "Parío y criao" inaugura festival y se estrena en tres salas virtuales de cine

Espectáculos | Pág. 19
"El agente topo" y otras 15 películas buscan un cupo en los prestigiosos premios Goya

Deportes | Pág. 18
CDA cayó ante Wanderers y corta invicto de once fechas

Deportes | Pág. 18
Esteban Paredes tras eliminación de Colo Colo: "Es un fracaso"

Deportes | Pág. 18
Sánchez salió lesionado y Vidal cometió penal en empate de Inter en Champions

Clasificados | Pág. 15
Tras la pandemia, el trabajo Automatizado alcanzará al humano en 2025, según el WEF
Clasificados | Pág. 15
Sube el prestigio de empleos cara a cara

Clasificados | Pág. 15
Iniciativa busca instalar más de 800 sirenas de alerta de tsunami en la zona costera de Chile: sólo cinco regiones tienen